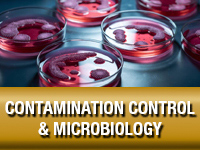
Contamination Control

Contamination Control -Training and Certification Programs
Showcase your expertise and commitment to excellence in contamination control by earning a distinguished professional certification from Biopharma Institute.
Showcase your expertise and commitment to excellence in contamination control by earning a distinguished professional certification from Biopharma Institute.
Choosing Biopharma Institute for your contamination control training showcases your commitment to receiving trusted, accurate, and high-quality instruction—delivered with a strong focus on ensuring the safety of the products and services provided to consumers and patients. Earning a certificate from Biopharma Institute is a mark of distinction, demonstrating your solid understanding of the subject matter and your dedication to regulatory excellence and compliance. Explore our comprehensive selection of contamination control certification courses and programs below, and take the next step toward advancing your skills and career.
 |
cGMP: Contamination ControlCourse ID: GMP06 |
 |
cGMP: Good Manufacturing Practice in Cleaning and SanitationCourse ID: CGMP03 |
 |
cGMP: Microbiology in the WorkplaceCourse ID: GMP03 |
 |
cGMP: Cleaning and SanitationCourse ID: GMP04 |
 |
OSHA: Environmental Cleaning-Exam RoomsCourse ID: OSHA-06 |
 |
cGMP: Hygiene, Cleaning, and Sanitation (Fundamentals)Course ID: CGMP01c |
 |
cGMP: Warehouse for PharmaceuticalsCourse ID: GMP02 |
 |
cGMP: Production ControlsCourse ID: GMP07 |
 |
cGMP: Quality Assurance and Quality Control (QA/QC)Course ID: GMP09 |
 |
OSHA: Infection Control for Healthcare ProfessionalsCourse ID: OSHA-13 |
The Benefits of Training with Biopharma Institute:
| Immediate Course Access: | Login details, instructions, and payment confirmation are emailed immediately upon online enrollment. |
| Self-Paced eLearning: | Enjoy 24/7 access to all course materials and assessments for 12 months. |
| Open Enrollment: | No prerequisites or prior work experience required to start. |
| Expert-Developed Content: | Courses are designed by subject matter experts (SMEs) in their respective fields. |
| Up-to-Date & Validated: | Training is regularly updated to meet current regulations and is third-party validated or accredited. |
| Optimized for Learning: | Courses feature voiceovers, intuitive navigation, reading materials, case studies, progress checks, and animations to boost knowledge retention. |
| Secure Access: | Encrypted connections, firewalls, and daily malware scans ensure security and system performance. |
| Flexible Assessments: | Multiple-choice exams can be retaken until a passing score is achieved. |
| Instant Certificates: | Certificates are issued instantly in secure PDF format with watermark, unique validation code, and QR code for verification. |
| Training Verification: | Certificates can be verified online using a QR code or unique ID. Digital badges are included with professional certifications. |
| Manager Access: | A secure portal allows managers to view and download enrollment reports, training records, account balances, and more. |
| SCORM-Compliant: | Courses can be integrated directly into most corporate Learning Management Systems (LMS). |
| Purchase Orders: | We accept POs from all companies. Request an invoice to start the procurement process. |
| Employer Reimbursement: | Some employers may cover training costs -check your company’s reimbursement policy. |
| Financial Assistance: | Payment plans are available for eligible learners, or purchase courses individually as needed. |
| Career Advancement: | Professional certifications highlight dedication to career growth, enhance resumes, provide interview talking points, and equip learners with practical job skills. |
Have Questions? Contact Us:
Use the form below to request more information about our programs. You can also request a quote for group training or an invoice to generate a company purchase order. For quotes or invoices, please include the course title(s) and the number of students.





